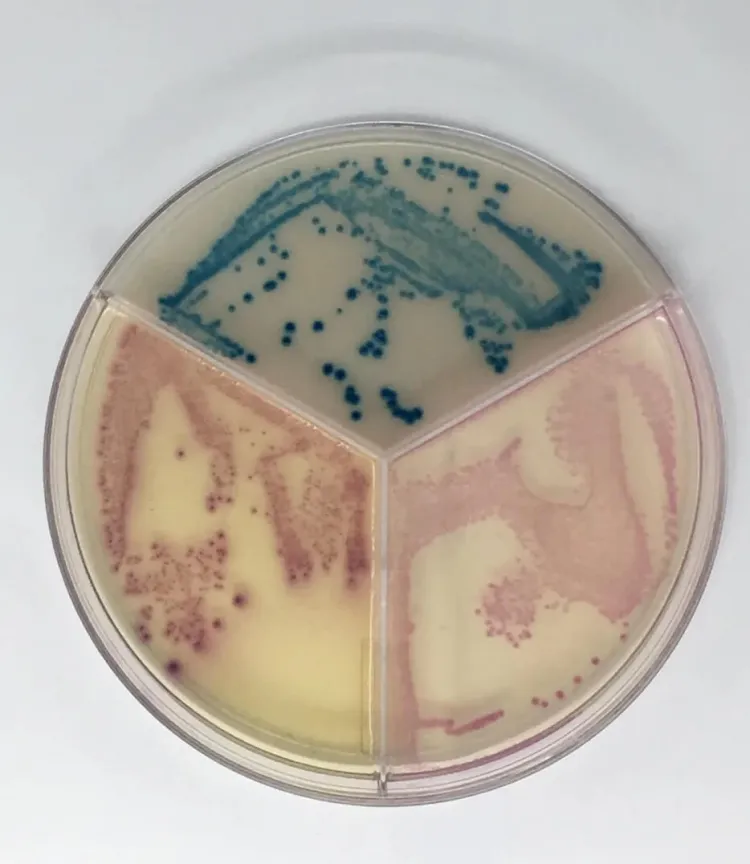
acumast plate

News
Billings Farm
Farm Background
Billings Farm, located in Woodstock, Vermont, was established in 1871 by Frederick Billings. What began as a 270-acre diversified operation with Jersey cattle, sheep, pigs, and other livestock expanded over time to nearly 1,000 acres. In 1983, the farm transitioned to a nonprofit working dairy farm and museum open to the public, welcoming more than 70,000 visitors annually. Today, Billings Farm milks 35-45 Jersey cows year-round and manages a total herd of approximately 80 head. Milk is marketed through Agri-Mark and Norwich Farm Creamery, and the farm partners with Grafton Village Cheese to produce three styles of Billings Farm-branded cheddar cheeses.
What management issue did this demonstration project address on your farm?
This project addressed two key management needs: on-farm milk testing and whole-herd disease testing. Together, these efforts supported the farm’s goal of improving disease detection and management in order to reduce risk, support on-farm decision making, and protect overall herd health.
Klebsiella mastitis has been an ongoing challenge on the farm, with a higher-than-desired proportion of high SCC and mastitis cases testing positive for this pathogen. The purchase of the Acu-Mast on-farm culture system allowed us to quickly and accurately identify mastitis-causing organisms, confirm diagnoses alongside DHIA lab results, and make more informed treatment and management decisions. The system has been easy to use and effective. Since its installation, we have experienced very few mastitis cases and maintained low bulk tank SCC.
In addition, this project improved our understanding of the herd’s overall disease status. Because we sell livestock to other farms, it was important to identify any diseases present so appropriate management practices could be implemented and progress toward disease eradication could begin. Whole-herd disease testing, conducted with veterinary support, identified several animals positive for Bovine Leukosis Virus (BLV), while confirming that no animals tested positive for BVD or Johne’s disease. These results allowed us to implement management practices to reduce disease transmission, including segregating positive cows, eliminating the use of milk or colostrum from BLV-positive animals, preventing cross-contamination during milking, and developing a clear culling plan. Overall, this project strengthened my ability as farm manager to proactively manage disease risk and maintain a healthy, marketable herd.
How did you track your progress or monitor your results during the project?
Progress was tracked using a combination of on-farm testing results, laboratory confirmation, herd records, and ongoing observation of herd health indicators. For mastitis monitoring, the Acu-Mast on-farm culture system was used to culture milk samples from cows with elevated SCC or clinical signs of mastitis. Results were interpreted using the color-coded tri-plates and scorecard, and select samples were sent to the DHIA laboratory on test day to confirm accuracy. On-farm culture results closely matched laboratory findings, validating the reliability of the system. Bulk tank SCC and individual cow SCC trends were also monitored, with the herd maintaining low SCC levels over the past year and very few mastitis cases since the equipment was installed.
Disease testing progress was tracked through whole-herd blood testing conducted with veterinary support and follow-up management actions. Initial results identified five animals positive for BLV and confirmed the absence of BVD and Johne’s disease. These findings informed the development and implementation of written management protocols, including segregation of positive cows, changes to colostrum and milk-feeding practices, milking order adjustments, and a planned culling timeline. Ongoing monitoring includes follow-up testing of younger animals as they reach appropriate age, tracking the culling status of positive cows, and regular communication with farm staff to ensure protocols are followed.
What were the findings from this project?
The Acu-Mast on-farm culture system confirmed that a cow near the end of her lactation with a high SCC had low levels of Klebsiella, which were consistent with the lab results from DHIA.
Whole-herd disease testing identified five animals positive for BLV and confirmed that all tested animals were negative for both BVD and Johne’s disease. These results allowed us to develop and implement management protocols to prevent cross-contamination and minimize disease transmission to other animals. The results also emphasized the importance of staff training and clear communication to ensure that everyone sticks to the protocol.
What benefits or challenges did you experience?
The biggest benefit of the Acu-Mast system is its ease of use and rapid results. While we have not needed to test many animals, having this tool allows us to quickly identify mastitis pathogens and respond appropriately. This is significantly faster than sending milk samples to a lab, which can take several days for results.
Whole-herd disease testing enabled us to identify BLV-positive cows and implement protocols to manage them effectively. This project also highlighted the importance of clear communication and ensuring that all staff understand and follow new protocols.
One of the main challenges was developing and implementing protocols to manage the BLV-positive cows and prevent cross-contamination. With multiple staff members involved in milking and animal care, consistent communication was essential. This project reinforced how critical frequent, clear communication is to successful farm management and ensuring everyone understands both the protocols and the reasons behind them.
Anything else?
This project has been extremely beneficial to the farm. Having the ability to test milk on-farm allows for rapid identification and treatment of mastitis, and the Acu-Mast system proved both easy to use and accurate.
Access to reliable data is key to making informed management decisions. Understanding the disease status of our animals allows us to develop and implement protocols to reduce disease risk. You can manage what you can measure; without test results, it is difficult to know where you stand. This process was neither difficult nor time-consuming, and it highlighted the potential cost of not knowing what diseases, whether mastitis pathogens or BLV, may be affecting the herd.

Rockbottom Farm and Optifeeders
Rockbottom Farm, located in Strafford, Vermont, is a certified organic dairy managing a herd of 80 Guernsey and Jersey cows. Since 2001, the farm has processed 100% of its milk into bottled milk and premium ice cream under the Strafford Organic Creamery brand. As the last remaining dairy farm in Strafford, Rockbottom Farm stewards more than 600 acres of pasture and crop land.
Through UVM Extension’s Dairy Herd Management Demonstration Fund, the farm received a grant to purchase two DeLaval Optifeeders. The Dairy Herd Management Technical Assistance team spoke with Earl and Jackson Ransom, owners of Rockbottom Farm, about their experience with the new equipment.
Q: What management issue did this demonstration project address on your farm?
A: When we installed our new milking parlor in 2022, we began feeding cows in a small pen as they exited the parlor to ensure they received grain appropriate for their production and nutritional needs. But the system was labor-intensive and slowed cow flow back to pasture. In our old flat-barn parlor, we could feed each cow individually during milking, which allowed for a quick exit from the parlor back out to pasture. The new stand-alone grain feeders in our freestall barn have allowed us to save labor, increase production, give cows free-choice access to grain while they are in the barn.
Because our parlor and the Optifeeders are both DeLaval systems, the software integrates seamlessly. We even receive alerts if a cow has not consumed her 24-hour grain allotment. The first two feeders have worked so well that we have since purchased four more, which will be installed this winter. Once all six feeders are operational, cows will be able to eat their grain and return to grazing more efficiently during the pasture season.
Q: How did you track progress or monitor results?
A: Integration between the parlor and feeder software has made tracking easy. After some initial calibration, the system now allows us to clearly see whether cows have consumed their full grain allotment.
We also use Cow Manager, an activity and rumination monitoring system that tracks health and behavior. This gives us the ability to evaluate how cows respond to feed changes, whether that is a change in grain or a new forage.
Q: What were the findings from this project?
A: The biggest finding so far is improved efficiency. We are using less grain than before installing the feeders and cows have increased production by a few pounds. The labor savings have also been significant—we estimate saving 2 hours per day compared to our previous system.
Q: What benefits or challenges did you experience?
A: While the feeders have been highly beneficial, we quickly realized that two feeders alone weren’t enough to achieve the level of cow-flow we hoped for, particularly during pasture season. This led us to purchase the additional four units, which we were able to source from a farm no longer using them.
We also identified a few design improvements from the first two installations that we plan to incorporate into the next four. With only a few months of use so far, the results have been very encouraging. We look forward to evaluating the full impact next spring, particularly how quickly cows can move from the parlor back to the pasture once all six feeders are in place.





Lawyer’s Dairy Goats, Enosburg Falls, VT
Lawyer’s Dairy Goats is a family-owned and operated goat dairy in Enosburg Falls, Vermont, located along the Missisquoi River with views of Jay Peak. Theresa and Lee Lawyer operate the dairy in partnership with Boston Post Dairy, the on-farm creamery managed by Theresa’s sisters, Anne Doe and Susan Blouin. The farm milks approximately 250 dairy goats and 6 dairy cows, selling most goat milk to Vermont Creamery while using the remaining goat milk and all cow milk for on-farm production of several award-winning artisan cheeses. In addition, Boston Post Dairy raises free-range chickens and produces maple products, goat milk soaps, lotions, and farm-fresh eggs, which are sold through the farm’s country store, and welcomes seasonal visitors for tours and farm experiences. The Dairy Herd Management Technical Assistance team spoke with Teresa Lawyer about their experience with the On-Farm Demonstration Project.
Management Challenge Addressed
This demonstration project addressed a persistent milk quality issue related to consistently elevated lab pasteurized counts (LPC). Despite repeated efforts to identify the root cause and assistance from multiple technical service providers, LPC levels remained high and inconsistent over time. A parlor audit conducted in December 2024 by Cornell’s Quality Milk Production Services and UVM Extension identified bacterial contamination in the farm’s well water as a contributing factor to the elevated LPC.
Prior to this project, the farm relied on periodic shocking of the well to reduce bacterial contamination. This approach provided only temporary improvement and created additional challenges, including potential impacts on animal health and continued detection of bacteria. Installation of a hydrogen peroxide water treatment system addressed this underlying water quality issue by continuously treating well water used for equipment and pipeline washing, with the goal of improving milk quality consistency, reducing bacterial contamination, and supporting animal health.
Evaluating Progress
Progress during the project was monitored using a combination of milk quality data and animal health indicators. LPC results were tracked over time and compared before and after installation of the hydrogen peroxide water treatment system to evaluate changes in milk quality and consistency. Trends in LPC served as the primary indicator for assessing system effectiveness.
In addition, the farm closely monitored animal health, including feed intake and the absence of adverse health events that had previously occurred following well shocking. Continued evaluation of water quality and equipment sanitation practices supported the interpretation of results. Together, these metrics allowed the farm to assess improvements in milk quality consistency and overall herd health throughout the project.
Project Findings
Findings from this project indicated that water quality was a critical factor influencing both milk quality and animal health on the farm. Following installation of the hydrogen peroxide water treatment system, LPC results showed a downward and more consistent trend, demonstrating improved milk quality and sanitation effectiveness. At the same time, the farm observed fewer animal health concerns, including improved feed intake and the elimination of adverse health events previously associated with well shocking.
These outcomes confirmed that treating the well water used for equipment and pipeline washing effectively reduced bacterial contamination and contributed to improved milk quality consistency and overall herd health, validating the hydrogen peroxide system as an effective management solution.
Project Challenges
A key challenge was properly calibrating the system to achieve optimal results. When set too high, the system caused excessive caustic fumes during the sanitizing wash cycle, while settings that were too low did not result in measurable improvements in milk quality. Fine-tuning the system required careful monitoring and adjustment to balance effectiveness with safe and practical day-to-day operation.
Farm Impact
The primary benefit of this project was identifying and implementing an effective, long-term solution to a milk quality challenge that the farm had experienced for an extended period.Installation of the hydrogen peroxide water treatment system resulted in improved milk quality consistency, as reflected by declining LPC counts, and eliminated the need for repeated well shocking.
With the installation of the hydrogen peroxide water treatment system, the farm no longer needs to shock the well every six months. While chlorine shocking provided only temporary improvements, the hydrogen peroxide system offers continuous water treatment. There was a steep learning curve associated with installation and calibration, and this system may not be appropriate for every farm. Producers considering this approach are encouraged to research available options and speak with other farms who have experience using similar systems before implementation.


UVM Extension’s Dairy Herd Management Technical Assistance Program Supports Farmers Statewide
Dairy Farm of the Year
Congratulations to the 2025 Vermont Dairy Farm of the Year: Four Girls Dairy, in Fairfax.
Upcoming Events
Monthly Dairy Updates
2026
2025
- December 2025 Dairy Update and December Charts (PDF)
- November 2025 Dairy Update and November Charts (PDF)
- October 2025 Dairy Update and October Charts (PDF)
- September 2025 Dairy Update and September Charts (PDF)
- August 2025 Dairy Update and August Charts (PDF)
- July 2025 Dairy Update and July Charts (PDF)
- June 2025 Dairy Update and June Charts (PDF)
- May 2025 Dairy Update and May Charts (PDF)
- April 2025 Dairy Update and April Charts (PDF)
- March 2025 Dairy Update and March Charts (PDF)
- February 2025 Dairy Update and February Charts (PDF) | Farm Grant Profile: Blue Ledge Farm (PDF)
- January 2025 Dairy Update and January Charts (PDF) | 2025 Milk Outlook (PDF) | Calf Health 102 (PDF)
2024
- December 2024 Dairy Update + November 2024 charts (PDF) + Farm Grant Profile: Kingdom Creamery + Milk Quality Testing Offered to Goat Dairy Producers in Vermont (PDF)
- November 2024 Dairy Update + November 2024 charts (PDF) + Raising Healthy Calves 101
- October 2024 Dairy Update + October 2024 charts (PDF) + Farm Grant Profile: Tup's Crossing Farm
- September 2024 Dairy Update and September 2024 charts (PDF)
- August 2024 Dairy Update and August 2024 charts (PDF)
- July 2024 Dairy Update and July 2024 charts (PDF)
- June 2024 Dairy Update (PDF)
- May 2024 Dairy Update (PDF)
- April 2024 Dairy Update (PDF)
- February 2024 Dairy Update (PDF)
- January 2024 Dairy Update (PDF)